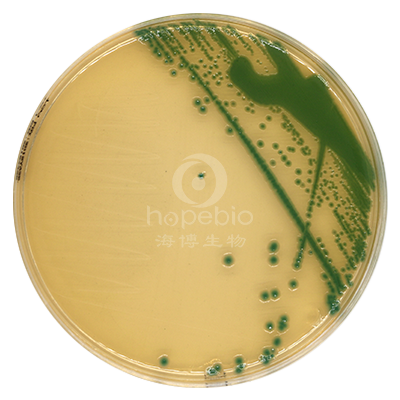
产品细节图片1

万千商家帮你免费找货
0 人在求购买到急需产品
- 详细信息
- 文献和实验
- 技术资料
- 保存条件:
请置于阴凉干燥处保存
- 保质期:
三个月
- 英文名:
Enterobacter Sakazakii Chromogenic Medium
- 库存:
100
- 供应商:
青岛海博生物
- 规格:
10个/包
阪崎肠杆菌显色培养基是青岛海博生物公司根据GB/T4789.40-2008生产的培养基,用于婴儿配方奶粉和其它食品中阪崎肠杆菌的快速检测。阪崎肠杆菌显蓝-绿色菌落,其它菌显无色或黄色。
成份(g/L)
| 胰蛋白胨 | 15.0 |
| 大豆蛋白胨 | 5.0 |
| 氯化钠 | 5.0 |
| 柠檬酸铁铵 | 1.0 |
| 硫代硫酸钠 | 1.0 |
| 脱氧胆酸钠 | 1.0 |
| 5-溴-4-氯-3-吲哚-α-D-吡喃葡糖甙 | 0.1 |
| 琼脂 | 15.0 |
| pH 7.3±0.2 25℃ | |
此配方可以进行改良或增加营养成份以获得最佳的结果。
操作步骤
1、用接种环接种mLST-Vm肉汤或EE肉汤增菌液 10μL 划线或涂布于阪崎肠杆菌显色平板上;
2、倒置放入培养箱 36℃ 培养 22-26h,典型的阪崎肠杆菌为蓝-绿色菌落;
3、挑取典型菌落做生化试验。
质量控制
1、外观
平板呈淡黄色固体培养基。
2、微生物试验 在 36℃ 培养 22-26 小时:
| 质控菌株 |
ATCC |
生长情况 |
菌落颜色 |
| 阪崎肠杆菌 |
29004 |
+++ |
蓝-绿色 |
| 金黄色葡萄球菌 |
25923 |
- |
- |
| 沙门氏菌 |
13076 |
+++ |
无色有黑色中心 |
| 大肠杆菌 |
25922 |
+++ |
淡黄色 |
| 肺炎克雷伯氏菌 |
10031 |
+++ |
无色 |
典型特征
典型的阪崎肠杆菌为蓝-绿色菌落,其它菌为无色、乳白色或黄色菌落。
![]() |
|
| 阪崎杆菌显色 阪崎杆菌ATCC29544 |
阪崎杆菌显色 阪崎杆菌CICC10318 |
注意
此培养基仅供实验室使用。
点击链接下载使用说明书:http://www.hopebiol.com/xiazai-download.asp?id=74
查看我公司所有显色平板菌落特征,请点击:显色平板菌落特征
阪崎杆菌显色培养基的微生物灵敏度试验:
按标签用法制备培养基,接种以下质控菌株,放置36±1℃需氧培养22-26小时。

风险提示:丁香通仅作为第三方平台,为商家信息发布提供平台空间。用户咨询产品时请注意保护个人信息及财产安全,合理判断,谨慎选购商品,商家和用户对交易行为负责。对于医疗器械类产品,请先查证核实企业经营资质和医疗器械产品注册证情况。
文献和实验实验步骤 1. 清洗器具用品:清洗所有的干胶条套件,包括胶条槽、盖片、托盘等。用Ettan IPGphor胶条槽清洗剂(Amersham Biosciences.),并用大量去离子水冲洗,自然干燥备用。 2. 第一向等电聚焦电泳 1) 加样和IPG干胶条再水化:采用样品加在再水化液中方法进行加样。24cm IPG胶条(PH3 -10Non-line )。银染蛋白质上样量为40ug-50ug。根据上样量计算出样品
;-D-半乳呋喃糖和1,4连结的3,6-脱水α-L-半乳呋喃糖。琼脂果胶是由许多更小的分子组成的异质混合物。它们的结构相似,但带硫酸根和羧基组分,凝胶能力差。 琼脂糖在水中一般加热到90℃以上溶解,温度下降到35-40℃时形成良好的半固体状的凝胶,这是它具有多种用途的主要特征和基础。琼脂糖凝胶性能通常用凝胶强度表示。强度越高,凝胶性能越好。质量较好的琼脂糖强度通常在1200克/cm2以上(1%胶浓度)。琼脂糖的凝胶性是由存在的氢键所致,凡是能破坏氢键的因素都能导致凝胶性
之处,因为琼脂是一种强 酸性物质,能造成严重的电渗现象,影响电泳的速度,而且琼脂所含可溶性 杂质难于除去。 琼脂凝胶电泳肺痨板式和柱式两种,一般采用平板式。其实验步骤如下: 1、配置缓冲溶液琼脂凝胶电泳常用缓冲溶液的pH 值多在6~9 之间, 离子强度为0.02~0.05。离子强度过高时,由于大量电流通过琼脂板将产生 热量,使板中水分大量蒸发而析出盐的结晶,甚至使用琼脂板断裂,电流中 断。常用的缓冲溶液,有硼酸盐缓冲液和巴比妥缓冲液。 2、制板制板常用的琼脂
技术资料暂无技术资料 索取技术资料